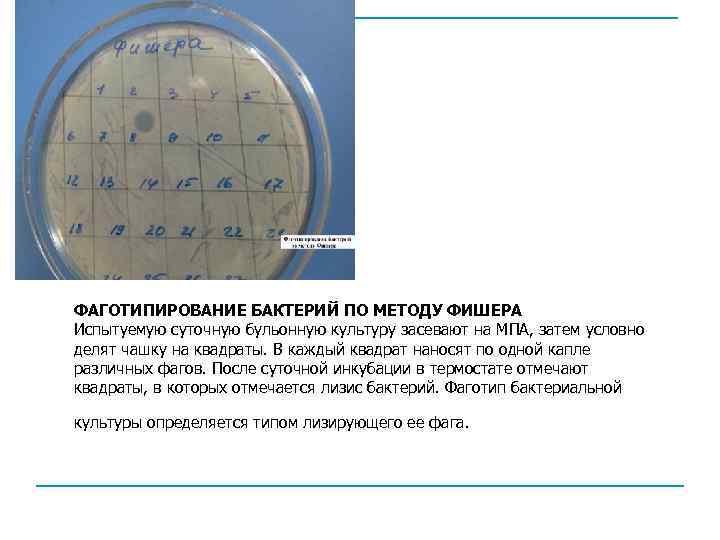
ФАГОТИПИРОВАНИЕ БАКТЕРИЙ ПО МЕТОДУ ФИШЕРА Испытуемую суточную бульонную культуру засевают на МПА, затем условно

М Бактериофаги.ppt
- Количество слайдов: 22

Бактериофаги Выполнила: студентка группы СД 1 -2 Падорина Лариса. .

Бактериофаги ( от лат. «phagos» - пожирающий) – вирусы бактерий, обладающие теми же характерными особенностями, что и другие вирусы. Характерные свойства фагов, как представителей царства Vira: n n фаги – неклеточные формы жизни содержат одну нуклеиновую кислоту – ДНК или РНК у них отсутствуют белоксинтезирующие системы и самостоятельный метаболизм облигатные внутриклеточные паразиты на генетическом уровне

СТРОЕНИЕ БАКТЕРИОФАГОВ. Покоящаяся, внеклеточная, форма – вирион. Внутриклеточная форма – вегетативная. Вирион Головка белковый футляр (капсид) + нуклеиновая кислота Отросток имеет белковую природу, отличается по длине и строению

Морфологические типы фагов. I – нитевидные фаги II – фаги без отростка III- фаги с аналогом отростка IV – фаги с коротким отростком V – фаги с длинным несокращающимся отростком VI– фаги с длинным сокращающимся отростком

Наиболее сложно устроены фаги с сокращающимся чехлом отростка, например, Т- четные фаги (Т 4) E. coli

Адсорбция фагов на бактериальной клетке

Взаимодействие фага с клеткой вирулентные фаги умеренные фаги вызывают продуктивную инфекцию, при которой происходит репродукция фагов и лизис бактериальной клетки характерна интегративная инфекция, но могут вызывать и продуктивную инфекцию

Этапы продуктивной инфекции: n n n 1 я стадия. Адсорбция фага на чувствительной клетке. Происходит при наличии комплементарных рецепторов в клеточной стенке бактерий или на концах нитей фагового отростка. 2 я стадия. Проникновение ДНК фага в бактериальную клетку. С помощью лизоцима осуществляется гидролиз участка клеточной стенки, чехол отростка сокращается и внутренний стержень прокалывает оболочку клетки. ДНК по каналу стержня проникает внутрь. 3 я стадия. Внутриклеточное развитие фага. ДНК бактериофага направляет клеточные системы на биосинтез компонентов, необходимых для репродукции фагов. Сначала идет синтез «ранних белков» – ферментов, осуществляющих репликацию ДНК, а затем «поздних белков» – белков головки, отростка и т. д.

n 4 я стадия. Морфогенез фага. Созревание фага разобщенный процесс. Отдельно формируются головки фага: вокруг ДНК строится капсид. Независимо образуется отросток: формируется базальная пластинка, к ней прикрепляется внутренний стержень и одевается чехлом. Отдельно синтезируются нити отростка. Затем составные части фага объединяются, образуя вирионы. n 5 я стадия. Лизис бактериальной клетки и выход фага. Фаговый лизоцим гидролизует клеточную стенку и осуществляет лизис клетки. Бактериофаги выходят в окружающую среду.

Этапы продуктивной инфекции.


Интегративная инфекция (лизогения) ДНК фага включается в кольцевую хромосому бактериальной клетки. Во время деления клетки профаг (интегрированная ДНК фага) реплицируется в составе клеточного генома и переходит в следующие поколения бактерий. Бактериальная культура, инфицированная умеренным фагом, сохраняет жизнеспособность и становится лизогенной. . Фаговая конверсия: процесс изменения свойств бактерии, под действием дополнительного набора генов, внесенных профагом в клетку, с приобретением ею токсигенных свойств (например, появление способности к образованию экзотоксина у возбудителей ботулизма, дифтерии, скарлатины).

Лизогенная инфекция.

ИНДИКАЦИЯ И ВЫДЕЛЕНИЕ БАКТЕРИОФАГА. В основе - принцип совместного посева исследуемого материала и чувствительной к искомому фагу культуры бактерий – тесткультуры. Метод обогащения с «подсевом» . 1) Исследуемый материал суспензируют и фильтруют. Фильтрат и гомологичную тест-культуру вносят в пробирку с МПБ. Инкубируют. 2) Содержимое пробирки освобождают от бактерий (центрифугирование, фильтрование). 3) Фильтрат засевают с тест-культурой на чашки с МПА. Инкубируют. На МПА на фоне роста бактериальной культуры появляются округлые пятна – негативные колонии фага.

4) Материал из пятна переносят в пробирку с МПБ, добавляют тест культуру, инкубируют. Фаги, размножившись в бактериях, вызывают их лизис и в пробирке получают фаголизат, содержащий множество фагов. 5) Фаголизат полностью освобождают от бактерий. Негативные колонии фага

Применение бактериофагов. 1. Для диагностики инфекционных заболеваний. а) для определения видовой принадлежности выделенной культуры бактерий. б) для фаготипирования – внутривидовой дифференциации чистой культуры бактерий. в) с целью индикации возбудителя непосредственно в материале от больного с помощью РНФ (применяют редко).

Фаготипирование Основа метода: с помощью типовых фагов метода дифференцируют культуры одного вида на основании их различной чувствительности к набору таких фагов, то есть выявляют фаготип, что позволяет выявить источник заболевания и пути его распространения. Фаготипирование S. typhi. Используют набор типовых Vi-фагов (А, B, C, D, E), каждый из которых лизирует культуры определенных фаговаров. Для типирования нужен фаг Vi-1, который лизирует все брюшнотифозные культуры, содержащие Vi- антиген, т. к. только такие культуры пригодны для постановки опыта.

Постановка опыта: 1) Бульонную культуру засевают в виде капель на поверхность МПА. 2) На высохшие капли культуры наносят типовые Vi-фаги, а также фаг Vi-1. Инкубируют. 3) Проводят учет результата опыта: культура должна полностью лизироваться фагом Vi-1 и определенными типовыми фагами, что и позволяет определить ее фаговар (с помощью таблицы). Фаготипирование S. typhi.

2. Для профилактики и лечения инфекционных заболеваний. Для лечения инфекционных болезней широко применяют антибиотики, но их неправильное использование вызывает осложнения. В качестве альтернативной терапии используют бактериофаги. Препараты бактериофага составлены из вирулентных бактериофагов широкого спектра действия, активных против антибиотикорезистентных бактерий. Их выпускают жидкими и лиофильно высушенными, в виде таблеток, кремов, мазей , свечей. Перед применением необходимо определить фагочувствительность возбудителя инфекции.

Наиболее употребляемые препараты бактериофагов. n n n Коли- протейный (смесь фаголизатов P. vulgaris и P. mirabilis) Стафилококковый бактериофаг Бактериофаг псевдомонас аеругиноза Сальмонеллезный бактериофаг Бактериофаг поливалентный (смесь фаголизатов стафилококков, стрептококков, E. coli, P. vulgaris и P. mirabilis)

n ТИТРОВАНИЕ БАКТЕРИОФАГА ПО МЕТОДУ ГРАЦИА 1, 0 мл фага смешивают в пробирке с 0, 5 мл бактериальной культуры и добавляют в эту же пробирку расплавленный МПА. Все содержимое выливают в чашку с МПА. Дают застыть верхнему тонкому слою и ставят в термостат. При встрече фага с бактерией, происходит лизис последней и образуется негативная колония фага. Такие негативные колонии затем подсчитывают для определения титра. Титром фага называют количество фаговых частиц в 1 мл препарата фага.
ФАГОТИПИРОВАНИЕ БАКТЕРИЙ ПО МЕТОДУ ФИШЕРА Испытуемую суточную бульонную культуру засевают на МПА, затем условно делят чашку на квадраты. В каждый квадрат наносят по одной капле различных фагов. После суточной инкубации в термостате отмечают квадраты, в которых отмечается лизис бактерий. Фаготип бактериальной культуры определяется типом лизирующего ее фага.
М Бактериофаги.ppt